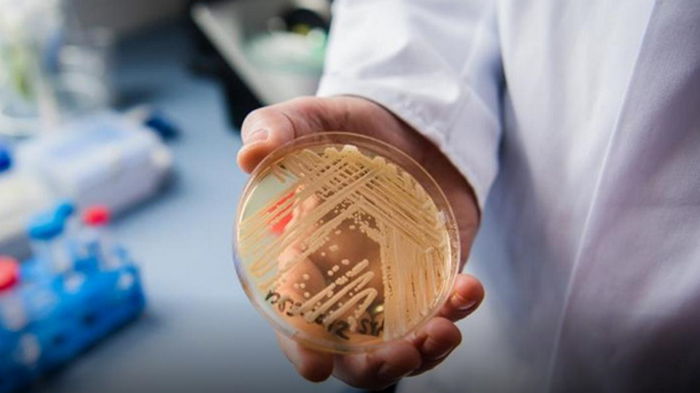

Ученые заявили, что пандемия может спровоцировать новую смертельную угрозу | |
![]() Фото: Global Look Press/Nicolas Armer Наибольшему риску заражения подвержены пациенты, в тело которых вставлены трубки для дыхания и кормления, а также различные катетеры.
Помимо резкого роста числа устойчивых к антибиотикам бактерий пандемия COVID-19 может вызвать массовые всплески заражения пациентов в стационарах грибком Candida auris. Об этом в воскресенье, 17 января, пишет Известия, со ссылкой на заведующего кафедрой клинической микологии, аллергологии и иммунологии СЗГМУ имени И.И. Мечникова Николая Климко. По его словам, этот патоген способен к быстрому внутрибольничному распространению и в большинстве случаев приводит к гибели пациентов в реанимации. В своих выводах ученый основывается на научной литературе, в которой есть данные о вспышках опасной грибковой болезни в коронавирусных стационарах. "В частности, специалисты отделения микробиологии Автономного университета Нуэво-Леон в Мексике описали случай грибковой инфекции в мае прошлого года в одной из больниц, перепрофилированных в коронавирусный госпиталь. Через три месяца после перехода от общего профиля к лечению исключительно COVID-19 в трех отделениях интенсивной терапии началась вспышка инфекции, от которой пострадали 12 пациентов. Все они находились на искусственной вентиляции легких. Летальность среди пациентов с COVID-19 и кандидемией (грибковым сепсисом) составила 83,3% даже при применении соответствующей противогрибковой терапии. Все изученные изоляты были устойчивы к стандартному лечению", - рассказывает ученый. Климко подчеркивает, что обычными микробиологическими методами идентифицировать данный вид грибков невозможно. Нужна масс-спектрометрия и другие методики, приборная база для которой есть только в крупных центрах, отметил специалист. Грибок Candida auris был впервые определен в качестве возбудителя заболевания у человека в 2009 году в Японии. Некоторые его штаммы являются устойчивыми ко всем трем основным классам противогрибковых препаратов, а его точное определение возможно только с помощью специальных лабораторных методов. Первый случай заражения Candida auris в Латинской Америке был выявлен в 2012 году в Венесуэле. Тогда возбудитель заболевания был выявлен сразу у 18 пациентов больницы в Маракайбо, 13 из которых были детьми. | |
|
18.01.2021 в 07:33 675 Наука | |
Сегодня читают
| Комментариев: 0 | |
Войдите, чтобы оставить комментарий.